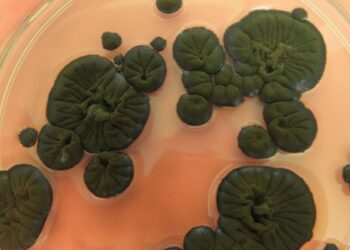
Çernobil mantarı radyasyonu yutup uzay kalkanı oluyor

Boğaziçi Üniversitesi ve Teknopark İstanbul ortaklığında çok yakında hizmete girecek olan Biyoküp Kuluçka Merkezi açılış için gün sayıyor. Mayıs ayında yapılması planlanan resmi açılış öncesi ilaç, tıbbi cihaz ve biyoteknoloji alanlarında çalışan bilim insanı ve girişimcilere çağrı yapan Teknopark İstanbul, Biyoküp’ün bir üniversite-sanayi iş birliği modeli sunduğuna dikkat çekiyor. Teknopark İstanbul’un Kuluçka Merkezi’nin üçüncü katında, toplam 1500 m2 alanda kurulan Biyoküp’de 12 adet laboratuvar, 8 adet temiz oda ve açık ofis alanları bulunuyor. 50 milyon liranın üzerinde yatırım yapılan Biyoküp’te, yürütülecek destek programları ile yılda 40 girişimin desteklenmesi hedefleniyor.
Girişimcilere özel olarak sağlanacak kimyasal dolaplar, çeker ocaklar ve güvenlik kabinlerinin bulunduğu Kuluçka Merkezinde, ortak laboratuvarlarda santrifüj, otoklav, inkübatör, ultra saf su cihazları gibi temel bazı cihazlar bulunuyor. Biyoküp’te 12 adet ıslak tezgah çalışmalarına uygun tasarlanmış laboratuvar, 8 adet modüler GMP-uyumlu temiz oda ve açık ofis alanları bulunuyor. Girişimcilere özel olarak sağlanacak kimyasal dolaplar, çeker ocakların ve güvenlik kabinlerinin bulunduğu kuluçka merkezinde, ortak laboratuvarlarda santrifüj, otoklav, inkübatör, ultra saf su cihazları gibi temel bazı cihazlar da bulunuyor. Biyoküp, biyoteknoloji alanında çalışacakların gelecekteki proje ihtiyaçlarına yönelik olarak mekansal altyapıda her detayı sunuyor.
Biyoküp Kuluçka Merkezi nedir?
Teknopark İstanbulGenel Müdürü Bilal Topçu, şimdiye kadar 50 milyon liradan fazla yatırım yapılan Biyoküp Kuluçka Merkezi için yatırımların halen devam ettiğini belirterek, şunları söyledi:

“Bu alan için Boğaziçi Üniversitesi ile çok yakın çalışarak örnek bir üniversite-sanayi iş birliği modeli oluşturduk. Yaşam Bilimleri ve Teknolojileri Uygulama ve Araştırma Merkezi (Boğaziçi LifeSci) yürütücülüğünde devam eden, Sanayi ve Teknoloji Bakanlığı koordinatörlüğünde yürütülen Avrupa Birliği’nin ‘Katılım Öncesi Mali Yardım Aracı IPA (Instrument for Pre-accession Assistance)’ başlıklı özel bir proje desteği ile bu alanda modüler temiz odalar kuruldu. İstanbul Sağlık Endüstrisi Kümelenmesi (İSEK), altyapının planlaması ve kurulumunun her aşamasında bize teknik destek verdi ve işletilme sürecinde de aktif yer alacak. İşletme modelinin tam olarak kurgulanıp desteklenmesi için, İstanbul Kalkınma Ajansı (İSTKA) da ek bir proje desteği sağladı. Bu proje ile girişimcilerimize, altyapı kullanım imkanına ek olarak teknik destek ve mentorluk vereceğiz.”
Amazon Lojistik Üssü ilk yılında bini aşkın kişi için istihdam yaratacak
“Katma değeri yüksek, sürdürülebilir ürünler ekonomiye kazandırılacak”
Konuyla ilgili konuşan Boğaziçi Lifesci Endüstriyel Projeler Koordinatörü ve İSEK Koordinatörü Prof. Dr. Cengizhan Öztürk de “Ülkemiz için hayati öneme sahip ve stratejik olarak öncelikli olduğunu, mevcut salgın ortamında yeniden perçinlediğimiz yaşam bilimleri alanında; katma değeri yüksek ve ülke ekonomisine katkı sunacak ürünleri, ülke ekonomisine hızla kazandırmayı hedefliyoruz. Biyoküp Kuluçka Merkezi, Türkiye sağlık girişimciliği ekosisteminin ihtiyaç duyduğu önemli bir altyapıyı dünya standartlarında sağlayacak ve bunu Biyokuluçka Destek Programı ile destekleyecek. Girişimci firmalarımızı ve bilim insanlarımızı cesur projeleri ile başvurmaya davet ediyoruz” dedi.

Biyoküp özellikle şu girişimcilere çağrı yapıyor:
- Yaşam bilimleri ve sağlık teknolojileri alanında faaliyet gösteren akademik girişimci firmalar, küçük ve orta büyüklükteki işletmeler
- Yaşam bilimleri ve sağlık teknolojileri alanında Ar-Ge yapan ve özellikle de pilot üretim aşamasına gelmiş erken aşama firmalar, girişimciler ve girişimci adayları
- Yaşam bilimleri ve sağlık teknolojileri geniş şemsiyesi altında bulunan çok farklı başlık altında çalışan (tıbbi cihaz, biyoteknoloji, moleküler biyoloji, in vitro diyagnostik, ilaç, aşı, biyoteknolojik odaklı muhtelif ürünler…) her seviyede girişimci firmalar
- Yukarıdaki başlıklarda özellikle temiz oda ve/veya GMP koşullarına uygun altyapılara ihtiyacı olan firmalar.
Biyoküp ile girişimcilere sağlanacak destekler ise şu şekilde:
- 7/24 modern çalışma alanları,
- Laboratuvar ve temiz oda altyapısı,
- Ortak cihazlı ve cihazsız laboratuvar altyapısı,
- Birebir danışmanlıklar, işletim destekleri ve İSO danışmanlıkları,
- Birebir mentorluk, satış ve tasarım desteği, finansal hukuk ve fikri haklar danışmanlık, iş geliştirme ve yönetim uygulamaları,
- Eğitimler, etkinlikler, girişim ve yetenek analizleri,
- Yatırımcı görüşmeleri, firma görüşmeleri, demo gününe katılım sağlama imkanı.